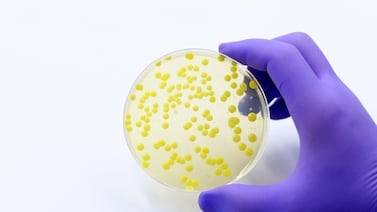
¿Qué es la bacteria Ralstonia y por qué preocupa a los hospitales del país?

Walmart sacó des sus tiendas varios tipos de pescado porque podrían estar contaminados con peligrosa bacteria, revise si usted compró estas marcas
Etiquetas bacteria
El Ministerio de Salud confirmó la presencia de pollo contaminado con una dañina bacteria.
El Ministerio de Salud reporta un brote de Ralstonia mannitolilytica en varios centros médicos del país, con 10 pacientes confirmados y medidas de bioseguridad reforzadas por la CCSS